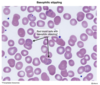
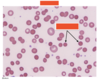
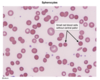
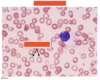
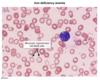
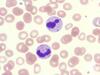
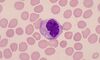

Perfil de PTH, calcio, fósforo y vitamina D en CKD
Hiperparatiroidismo secundario:
1. TFG disminuida (sobre todo <20), retiene fósforo y disminuye conversión de 25-OH-vitamina D a 1,25-di-OH-vitamina D (calcitriol)
2. Hiperfosfatemia activa liberación de fibroblast growth factor 23 del hueso: disminuye producción de calcitriol, absorción de calcio intestinal y fósforo renal/intestinal.
3. Hipocalcemia e hiperfosfatemia aumentan liberación de PTH
Perfil de PTH, calcio, fósforo y vitamina D en hiperparatiroidismo primario
Elevación de PTH: aumenta resorción ósea, reabsorción de calcio en el intestino/riñón, excreción de fósforo renal y activación de vitamina D en el riñón
- PTH elevada
- Hipercalcemia
- Hipofosfatemia
- Calcitriol elevado
Perfil de PTH, calcio, fósforo y vitamina D en hipoparatiroidismo
PTH disminuida: disminuye resorción ósea, disminuye reabsorción de calcio en el intestino/riñón, disminuye excreción renal de fósforo y activación de vitamina D en el riñón
- PTH disminuida
- Hipocalcemia
- Hiperfosfatemia
- Calcitriol disminuido
Perfil de PTH, calcio, fósforo y vitamina D en exceso de calcitriol
Exceso de 1,25-di-OH-vitamina D (sarcoidosis, TB, suplementos): aumenta reabsorción intestinal de calcio y fósforo, suprimiendo PTH
- PTH disminuida
- Hipercalcemia
- Hiperfosfatemia
- Calcitriol elevado
** Sarcoidosis y TB: macrófagos expresan 1-alfa hidroxilasa
Perfil de PTH, calcio, fósforo y vitamina D en déficit de vitamina D
Déficit de 25-OH-vitamina D: disminuye absorción dietaria de calcio. Esto aumenta PTH, lo cual aumenta excreción intestinal de fósforo y menor reabsorción renal de fósforo. El efecto de la PTH sobre el riñón puede restablecer niveles de calcitriol por aumento en la conversión.
- PTH aumentada (hiperparatiroidismo 2º)
- Hipocalcemia
- Hipofosfatemia
- Calcitriol normal o bajo
Paso enzimático por radiación UV en metabolismo de la vitamina D
7-dehidrocolesterol (provitamina D3) a ergocalciferol (vitamina D2) y colecalciferol (vitamina D3)
Manifestaciones clínicas de la deficiencia de vitamina D
Osteomalacia: mialgias, dolor óseo, debilidad muscular, calambres, anormalidad de la marcha, riesgo de fracturas
Causas de deficiencia de vitamina D
- Vida predominantemente nocturna
- Piel muy pigmentada (no penetra UV)
- Baja exposición solar
Reguladores de 1-alfa hidroxilasa
- PTH la activa
- Calcio la inactiva
Presiones normales en cavidades cardíacas
- AD: <5
- VD: 25/<5
- Arteria pulmonar: 25/8
- AI: <12
- VI: 120/<12
- PCWP: 4-12 mmHg
- Aorta: 120/80
Causa de aumento de la compliance pulmonar
EPOC (por enfisema)
Causa de disminución de la compliance pulmonar
Enfermedad pulmonar restrictiva
Causa de aumento del espacio muerto
TEP, enfisema, SDRA
Causa de disminución de la capacidad de difusión pulmonar
Fibrosis pulmonar
Causa de aumento de la resistencia de la vía aérea
Broncoespasmo (asma)
Causa de aumento de la capacidad residual funcional
EPOC
Efecto del volumen tidal sobre el espacio muerto
- Aumento VT: disminuye espacio muerto
- Disminución VT: aumento del espacio muerto
Resultados en prueba de desmopresina y restricción de agua
- Diabetes insípida central y nefrogénica completa: osm urinaria persiste baja a pesar del aumento de osm sérica con la restricción hídrica. Una vez se administra desmopresina, en la DI central se aumenta rápidamente la osm urinaria, mientras que en la DI nefrogénica completa persiste igual.
- DI nefrogénica parcial: aumento lento pero progresivo de la osm urinaria con el aumento de la osm sérica. No logran un mayor aumento con la administración de desmopresina.
- Polidipsia primaria: aumento similar a DI nefrogénica parcial. Logra un aumento con la administración de desmopresina. Historia psiquiátrica/medicamentos.

En pacientes con ductus arterioso persistente, la PaO2 es mayor en donde comparado con niños sanos
Arteria pulmonar
Papel de las incretinas
Liberación de insulina en respuesta a una carga oral de glucosa, sin importar niveles de glicemia
Ejemplos de incretinas
GLP1 (glucagon like-peptide 1) y GIP (glucose dependent insulinotropic peptide)
¿Dónde se producen las incretinas?
Páncreas
¿Dónde se produce el insulin-like growth factor?
Hígado (estimulación por GH)
¿Dónde se produce la somatostatina?
Estómago, intestino delgado y páncreas (células D)